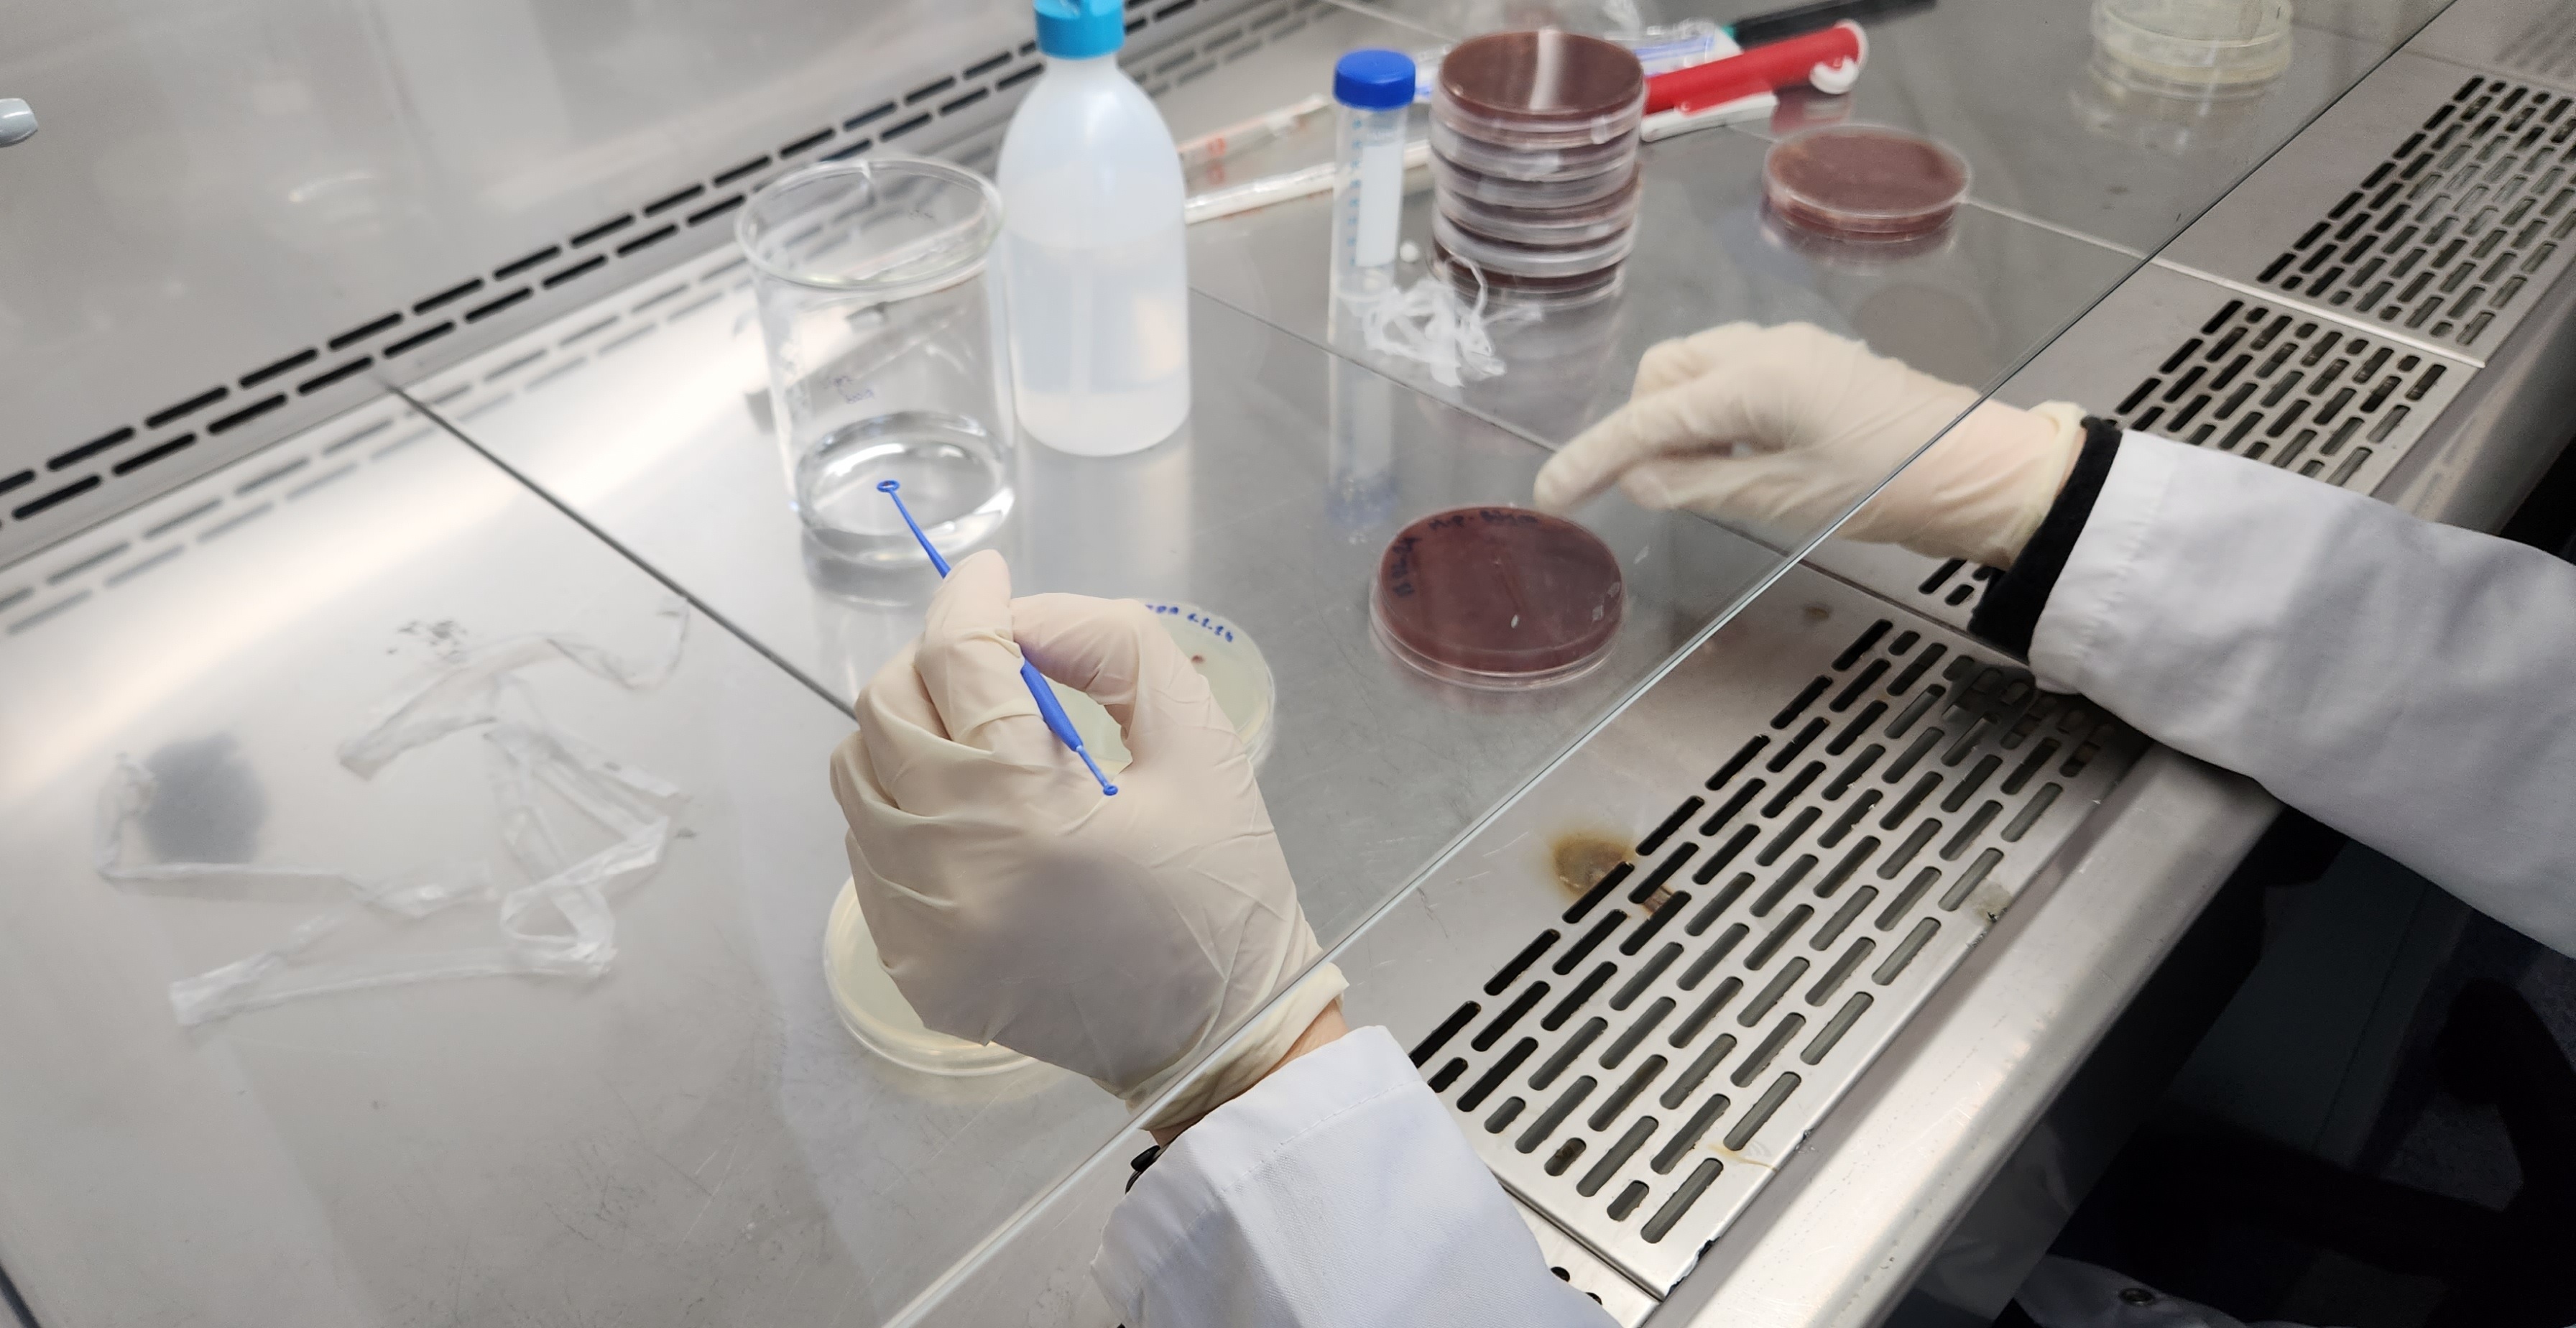
ARLAB1

Learn about our mission and our team.
We envision being a global food technology company that designs and produces innovative functional foods, beverages, and nutritional supplements by integrating deep technologies with traditional culture and culinary heritage, thereby enhancing the expectations of people of all ages for a healthy and energetic life.
Our team combines scientific expertise with culinary passion.

Contact us to discuss how we can support your food research needs.
Contact Us